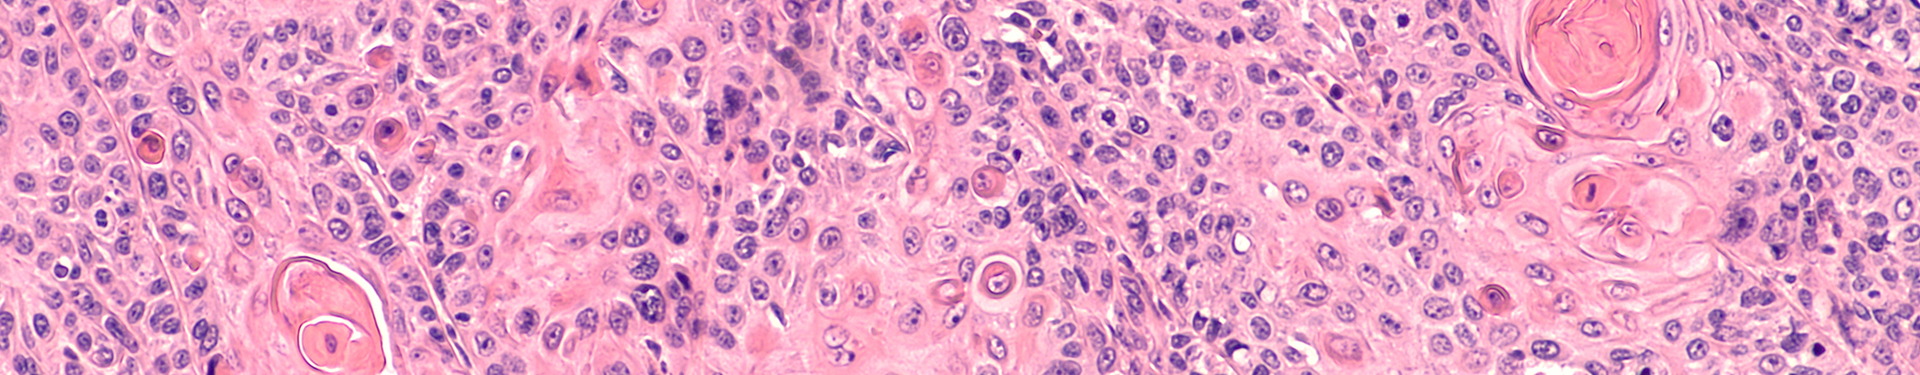

Un tema del que todos debemos estar enterados y para el que, sin duda, debemos mantenernos alerta es el Virus del Papiloma Humano, del cual, muy seguramente, has escuchado hablar y puede generarte muchas dudas.
En este artículo te contaremos qué es, de qué manera se presenta y te daremos algunos consejos para que disminuyas la probabilidad de contraerlo, así que, ¡sigue leyendo!
¿Qué es el VPH?
Aunque su nombre general se refiere a “virus” en singular, este realmente se refiere a un grupo de cerca de 200 tipos de virus relacionados entre sí y se propagan a través del contacto con otras personas.
Al menos 40 de ellos son de transmisión sexual y se presentan en los genitales, haciendo que también se muestre riesgo de que evolucione y se convierta en un cáncer, por lo que debes ser muy cuidadosa con los síntomas y mantenerte prevenida.
¿Cuáles son los síntomas de la infección por el VPH?
El VPH se puede manifestar diferente en cada persona y todo depende mucho del tipo de virus que se hayas adquirido, por eso debes estar alerta a cualquiera de los síntomas que te vamos a mencionar y asistir donde un profesional de la salud si es que tienes sospechas que puedan poner en riesgo tu integridad.
Verrugas genitales
Estas se empiezan a manifestar normalmente como pequeñas protuberancias en la zona genital. Si notas un cuerpo extraño de tamaño moderado y con textura, debes ir a consultar.
En las mujeres se presenta comúnmente en la zona de la vulva o cerca del ano, y en los hombres puede presentarse en el pene, alrededor de él, o por el ano.
Verrugas comunes

Aunque esta parezca una lesión bastante común que más que afectar los temas de salud, es antiestética, también en ocasiones puede venir acompañada de dolor, incomodidad, e incluso en ocasiones con pequeños sangrados o supuración de secreciones.
Es común que este tipo de lesiones aparezcan en los dedos y las manos en forma de bulto corrugado.
Verrugas plantares
Estas, como su nombre lo dice, suelen aparecer en las plantas de los pies o alrededor de ellas, generando molestias e incomodidad al caminar.
Verrugas planas
Este tipo de verruga se puede presentar en cualquier zona del cuerpo, y se caracterizan por no tener una protuberancia o bulto muy notorio, sino que más bien se identifican por su textura áspera y arrugada sobre la piel.
¿Cuáles son los síntomas de las verrugas genitales?
Además de su apariencia que puede llegar a ser molesta y antiestética, las verrugas causadas por el VPH no suelen generar síntomas notorios a menos de que estén en un punto demasiado avanzado y que hayan causado alteraciones en las células.
Si el VPH se detecta a tiempo, se corre menos riesgo de que se convierta en una infección peligrosa que se llegue a convertir en cáncer.
¿Puede el VPH causar cáncer?
Una infección sexual mal cuidada puede ser, por supuesto, demasiado peligrosa. Por ejemplo, si al notar la aparición de verrugas en tus zonas genitales no asistes a revisión médica, puede ser que esta infección avance y altere tus células, produciendo un cáncer.
Cáncer de cuello uterino
Aunque es muy común que las personas con vida sexual activa adquieran el VPH, una infección mal tratada puede derivar en este tipo de cáncer.
Se presenta con más frecuencia en personas mayores de 30 años que, tal vez, han tenido el virus presente por mucho tiempo y que no se diagnosticó en el momento oportuno, o que no asistieron al tratamiento adecuado para disminuir sus síntomas.
Cáncer de ano
Las células cancerosas no distinguen de ningún lugar para aparecer, por eso en el ano y sus alrededores también es posible encontrar un tumor.
Lo podrías identificar si estás teniendo sangrados repentinos por esa zona, molestias o bultos incómodos.
La mayoría de los casos de cáncer de ano se presentan a raíz del virus del papiloma humano.
Cáncer de boca o garganta
Este tipo de cáncer se puede identificar, por su zona, además de la aparición de verrugas, por llagas o protuberancias incómodas en la boca y la garganta.
Algunas de estas úlceras pueden aparecer por el VPH y generar mucha molestia, y debes saber que se pueden transmitir por medio de la saliva; así que, no tienes que enfocar todo tu cuidado en evitar relaciones sexuales por penetración, porque también es probable que se transmitan infecciones por un beso e incluso por beber de una misma botella de agua.
¿Cómo puedo reducir las probabilidades de contraer el VPH?

La que más conocemos y que incluso estamos cercanos a ella desde la niñez, es la vacuna contra el VPH; esta vacuna es segura y eficaz, y lo ideal sería vacunarse antes de tener la primera relación sexual, pero si no lo hiciste en la infancia, se recomienda que incluso hasta los 26 años puedes aún aplicarla para obtener sus beneficios.
Además, ¡y como regla de oro! Ten una vida sexual responsable y usa protección siempre que vaya a tener relaciones . El uso del condón en cada encuentro íntimo es fundamental para tener seguridad, no solo de prevención de embarazos, sino también de enfermedades de transmisión sexual.
Aunque uses condón, puede que el contacto con otras zonas del cuerpo transmitan el virus, así que no tiene una efectividad completa, pero sí ayuda a disminuir los riesgos.
Además, una correcta higiene en las zonas genitales es esencial; para esto, limpiar de manera correcta la zona íntima es clave, además de, si eres mujer, usar los productos adecuados para el cuidado de tu zona íntima, como Protectores Diarios Discreet, que te mantendrán segura y protegida en todo momento.
Consejos extra
Nunca está demás que protejas tu salud de manera integral, realizando ejercicios frecuentemente, alimentándote de manera correcta y socializando con la comunidad para que tu salud mental sea positiva.
Además, no es necesario enfocar nuestra energía y tiempo angustiándonos porque pudimos contraer el VPH o estar en riesgo; esto es algo que, sin duda, puede sucederle a cualquiera, la clave está en saber darle un correcto manejo a los síntomas y así evitar que estos avancen.
Fuentes
https://www.cdc.gov/std/spanish/vph/stdfact-hpv-and-men-s.htm
https://www.mayoclinic.org/es/diseases-conditions/hpv-infection/symptoms-causes/syc-20351596
Dirigido a:

MUJERES

Comentarios